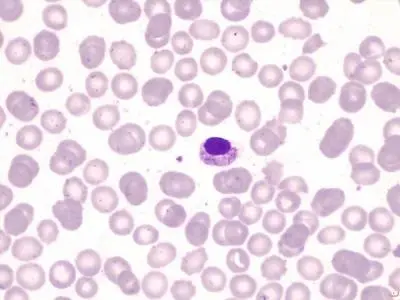
Bacteria Capnocytophaga canimorsus. FOTO: Neus Amer, Irene Vázquez, Hospital Universitario Son Llàtzer, Palma de Mallorca, España. Grupo Español de Citología Hematológica.

Marie Trainer, una mujer de 60 años residente en Ohio, Estados Unidos, jamás imaginó que unas vacaciones con su esposo y amigos en República Dominicana, en mayo de 2019, cambiarían su vida para siempre. Días después de regresar a casa, despertó en una cama de hospital sin brazos ni piernas y sin poder hablar.
Al llegar de su viaje, Marie fue recibida con muestras de cariño por parte de su perra Taylor, una pastor alemán de dos años. El reencuentro incluyó besos y lamidos, algo habitual entre ambas y que no generó preocupación en ese momento.
Conozca: Así vive Odie, el perro rescatado en el metro de Medellín, que encontró familia luego de 10 años
Pocos días después, Marie comenzó a sentirse mal. Presentó dolor estomacal, dolor de espalda y un fuerte malestar general. En cuestión de horas, su estado empeoró de forma acelerada hasta que empezó a perder la conciencia.
Ante la gravedad de los síntomas, su esposo la trasladó de urgencia a un hospital. Sin embargo, su condición continuó deteriorándose y los médicos decidieron remitirla en ambulancia aérea a otro centro médico para realizar estudios especializados.
Para entonces, Marie ya se encontraba inconsciente y en estado crítico.
Una posible enfermedad contraída en República Dominicana
En un primer momento, los médicos creyeron que Marie había contraído una enfermedad tropical durante su estadía en el Caribe. Por ello, le practicaron múltiples análisis de sangre mientras permanecía bajo cuidados intensivos.
No obstante, los resultados descartaron esa hipótesis. El origen de la infección no estaba relacionado con el viaje, sino con un contacto ocurrido al regresar a casa.
La bacteria presente en la saliva de los perros
La familia fue informada de que Marie había contraído una infección causada por la bacteria Capnocytophaga canimorsus, un microorganismo que habita de forma natural en la boca de perros y gatos.
Según explicaron los especialistas, la bacteria ingresó a su organismo a través de una pequeña herida en el brazo. Durante las vacaciones, Marie se había hecho un rasguño al rozar un muro de ladrillo, lesión que no le produjo dolor ni despertó alarma.
Al regresar a casa, su perra lamió esa herida, permitiendo que la bacteria entrara al torrente sanguíneo.
Avance de la infección: Sepsis, gangrena y amputaciones
La infección avanzó de manera agresiva y derivó en sepsis, una complicación grave que puede comprometer múltiples órganos. Mientras Marie permanecía en coma, su piel comenzó a cambiar de color y a desarrollar gangrena.
Siga leyendo: En apenas un mes de operación, el nuevo tramo de la vía al mar entre Vegachí y Remedios se llenó de animales muertos
Los médicos intentaron salvar sus extremidades, pero el daño fue irreversible. Tras cerca de nueve días inconsciente, Marie despertó rodeada de sus seres queridos. Fue un psicólogo del hospital quien le explicó que, para salvarle la vida, los cirujanos habían tenido que amputarle ambos brazos y ambas piernas.
En total, permaneció alrededor de 100 días hospitalizada y fue sometida a 13 cirugías. La infección incluso alcanzó la punta de su nariz.
Un largo proceso de rehabilitación
Tras salir del hospital, Marie inició un extenso proceso de rehabilitación. Aprendió nuevamente a caminar con prótesis y a realizar tareas básicas como sentarse, girarse y desplazarse.
A pesar de la magnitud de lo ocurrido, aseguró que no culpa a su perra y que entiende que se trató de una circunstancia desafortunada. Durante su hospitalización, Taylor fue llevada en varias ocasiones a visitarla, lo que, según Marie, fue un apoyo emocional clave en su recuperación.

Regístrate al newsletter
Regístrate al newsletter